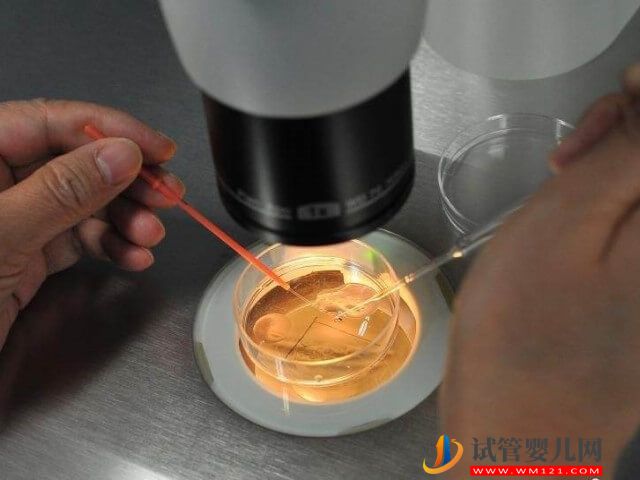
本溪試管5個鮮胚養囊一般可以成功幾個？(圖1)

?
风间由美性色一区二区三区|
欧美日韩午夜剧场|
亚洲综合激情视频|
青草在线视频在线观看|
精品国产123|
亚洲 欧美 视频|
91tv官网精品成人亚洲|
成人区精品一区二区|
av先锋下载|
一二三四区精品视频|
特大黑人巨人吊xxxx|
天堂va在线高清一区|
2018中文字幕一区二区三区|
九色国产视频|
久久久激情视频|
69久久精品无码一区二区|
成人四虎影院|
久久久视频精品|
最新亚洲精品国自产在线观看|
成人动漫中文字幕|
久久久精品麻豆|
亚洲天堂av影院|
不卡av电影院|
免费视频拗女稀缺一区二区|
东方欧美亚洲色图在线|
亚洲色图38p|
欧美成人黑人|
欧美富婆性猛交|
日韩簧片在线观看|
久久久久成人黄色影片|
国产成人精品一区二区在线小狼
|
欧美视频国产精品|
99久久久免费精品|
久久免费大视频|
久久精品一区二区三区不卡免费视频|
在线观看成年人视频|
欧美性生活大片视频|
国产一级淫片a|
狠狠色狠狠色综合日日tαg|
色综合久久88色综合天天提莫|
九九热视频在线观看|
欧美不卡一二三|
中文字幕一区二区三区波野结|
日日夜夜精品视频免费|
亚洲国产成人精品无码区99|
国产丝袜精品丝袜|
久久亚洲精品网站|
免费精品国产自产拍在|
国产精品乱码人人做人人爱|
亚洲国产无码精品|
成人久久久久|
免费在线成人av|
麻豆app在线观看|
亚洲精品美女久久久|
亚洲精品无遮挡|
99久久99久久久精品齐齐|
超碰人人cao|
国产精品99久久免费观看|
亚洲va欧美va国产综合久久|
视频免费裸体网站|
日韩三级.com|
99这里有精品视频|
av在线播放一区二区三区|
秋霞午夜鲁丝一区二区|
红杏aⅴ成人免费视频|
caoporen国产精品|
一级毛片在线播放|
日韩精品免费综合视频在线播放
|
中文字幕视频在线播放|
国产在线精品一区二区
|
26uuu精品一区二区三区四区在线|
中文字幕在线播放一区二区|
天堂俺去俺来也www久久婷婷|
国产精品一区在线播放|
国产福利在线观看|
一区二区三区黄色|
麻豆精品国产自产在线|
亚洲黄色片在线观看|
91麻豆精品成人一区二区|
影音先锋久久精品|
婷婷无套内射影院|
福利一区和二区|
国产日韩av在线播放|
写真福利片hd在线观看|
亚洲成年人在线|
日韩一级片免费在线观看|
国产日韩欧美激情|
夫妻性生活毛片|
欧美中文日韩|
中文字幕网av|
欧美美女在线直播|
欧美一区二区三区成人久久片|
黄色成年人视频在线观看|
欧美激情久久久|
成人拍拍拍在线观看|
欧美一级久久久久久久大片|
欧美 日韩 国产 成人 在线 91|
国产日韩欧美综合一区|
三级黄色在线观看|
日韩精品电影一区亚洲|
中文字幕资源在线观看|
中文字幕中文字幕精品|
在线观看一区二区三区三州|
自拍一区在线观看|
国产日本欧美一区|
狠狠狠综合7777久夜色撩人
|
国产精品视频流白浆免费视频|
欧美日韩国产精品一区二区三区四区
|
99久久久无码国产精品性|
欧美不卡视频|
欧美视频第一区|
精品福利网址导航|
一本一本a久久|
欧美动物xxx|
亚洲最大福利网站|
伊人免费在线|
97在线看免费观看视频在线观看|
能在线观看av网站|
亚洲欧美在线一区二区|
91激情视频|
69堂成人精品免费视频|
亚洲免费网站观看视频|
亚洲国产精品久久久久秋霞影院|
精品久久久久久久久久久国产字幕|
不卡电影一区二区三区|
国产精品成人69xxx免费视频|
美腿丝袜亚洲色图|
99久久人妻精品免费二区|
欧美特黄一级|
色戒在线免费观看|
婷婷综合伊人|
成人羞羞国产免费网站|
久久99国产精品视频|
国产情侣第一页|
9l视频自拍蝌蚪9l视频成人|
四虎一区二区|
日韩久久一区|
香蕉久久免费影视|
欧美爱爱视频|
水蜜桃亚洲一二三四在线|
韩国精品视频在线观看|
欧美韩国日本精品一区二区三区|
美女100%一区|
久久国产精品免费一区|
黑人巨大亚洲一区二区久|
国产福利久久|
樱花草涩涩www在线播放|
成人自拍爱视频|
2021天堂中文幕一二区在线观|
91九色蝌蚪嫩草|
91视频欧美|
国产精品一区二区三区四区五区|
97蜜桃久久|
国产精品对白刺激久久久|
cao在线视频|
国产成人成网站在线播放青青|
成人观看网址|
国产欧美一区二区三区不卡高清|
日韩电影毛片|
精品一区二区日本|
成人黄色免费网站|
亚洲欧美国产不卡|
99ri日韩精品视频|
日韩视频免费播放|
欧美人与拘性视交免费看|
久草青青在线观看|
9999国产精品|
男人午夜视频在线观看|
日韩午夜精品|
国产中文字幕一区二区|
久久精品国产亚洲aⅴ|
无码人妻精品中文字幕|
caoporn国产一区二区|
日韩av大片在线观看|
国产精品伦一区|
国产精品-色哟哟|
精品国产电影一区|
最近免费中文字幕在线第一页
|
亚洲欧美激情诱惑|
久久精品成人av|
国产一区二区三区日韩|
九九热国产在线|
国产丝袜在线精品|
国产毛片久久久久|
一本到不卡免费一区二区|
717影院理论午夜伦不卡久久|
日韩视频一区二区三区在线播放|
日本免费网站|
www欧美日韩|
日本一区视频|
国产日韩欧美91|
在线高清av|
亚洲精品第一区二区三区|
精品av导航|
一区二区在线播放视频|
99精品国产在热久久下载|
国产jk精品白丝av在线观看|
丁香激情综合国产|
无码人妻一区二区三区免费|
一区二区三区高清|
97理论电影|
日韩精品在线观看网站|
领导边摸边吃奶边做爽在线观看|
热re91久久精品国99热蜜臀|
黄网在线免费看|
日韩一区二区电影在线观看|
乱亲女h秽乱长久久久|
亚州精品一二三区|
久久裸体视频|
九九九在线视频|
亚洲品质自拍视频网站|
推川ゆうり中文亚洲二区|
欧美videossexotv100|
avlululu|
国产精品黄页免费高清在线观看|
中文字幕人成乱码在线观看|
欧美性视频在线播放|
久久理论电影|
免费观看av网站|
91麻豆免费观看|
а√天堂资源在线|
日韩精品专区在线|
秋霞在线观看av|
国产精品激情av在线播放|
中老年在线免费视频|
久久福利一区二区|
韩国亚洲精品|
999精品视频在线观看播放|
综合在线观看色|
四虎海外永久免费网址|
亚洲午夜激情免费视频|
成全电影播放在线观看国语|
精品久久sese|
亚洲人成网亚洲欧洲无码|
无码人妻一区二区三区在线|
国产sm精品调教视频网站|
一区二区视频免费观看|
欧美日韩视频不卡|
在线观看免费播放网址成人|
日韩暖暖在线视频|
日韩另类视频|
日本www高清视频|
蜜臀精品一区二区三区在线观看
|
久久免费观看视频|
av成人影院在线|
中文精品无码中文字幕无码专区
|
一区二区三区日韩在线观看|
欧美久草视频|
久久深夜福利免费观看|
99福利在线|
在线视频不卡一区二区|
欧美精品激情|
欧美国产精品一二三|
亚洲午夜在线视频|
色先锋资源网|
热久久免费视频精品|
成人午夜一级|
在线免费观看视频黄|
国产一区二区三区四区五区美女
|
丰满肉嫩西川结衣av|
亚洲精品美女在线|
www.久久热.com|
特级西西444www大精品视频|
欧美一区久久|
欧美成人精品欧美一级|
黑人欧美xxxx|
18成人免费观看视频漫画|
国产精品一区二区性色av|
试看120秒一区二区三区|
亚洲欧美日韩中文字幕在线观看|
99久久久久免费精品国产|
欧美激情精品在线
|
日韩一级免费在线观看|
韩国精品一区二区|
www.国产欧美|
一区二区欧美久久|
成人在线免费观看黄色|
老太脱裤子让老头玩xxxxx|
蜜桃久久精品一区二区|
国产欧美久久久|
亚洲日本欧美日韩高观看|
国产欧美久久久久久久久|
男人天堂a在线|
免费精品视频最新在线|
国产精品爽爽久久|
亚洲欧美日韩一区在线|
美洲精品一卡2卡三卡4卡四卡|
黄色国产一级视频|
激情综合网最新|
亚洲女同志亚洲女同女播放|
中文字幕一区二区精品|
黄色激情在线播放|
久久久久国产一区|
wwww国产精品欧美|
麻豆国产视频|
日本a级片电影一区二区|
caoporn成人免费视频在线|
精品人妻一区二区三区蜜桃视频|
一区二区三区精品在线观看|
激情亚洲色图|
国精产品一区二区|
欧美日韩影院|
波多野结衣电车|
亚洲欧美日韩中文视频|
免费看男女www网站入口在线|
三年中国国语在线播放免费|
91麻豆国产自产在线观看|
国产黄色麻豆视频|
成人a视频在线观看|
国产日韩欧美一区二区三区|
免费中文字幕在线|
7777精品伊人久久久大香线蕉
|
色视频www在线播放|
亚欧精品在线|
久久中文在线|
亚洲AV午夜精品|
超碰91人人草人人干|
日本在线一区二区|
黄色工厂在线观看|
欧美午夜精品伦理|
天堂资源最新在线|
日韩中文字幕在线不卡|
国产精品亚洲成人|
伦理欧美一区|
91精品在线看|
亚洲h色精品|
成人毛片一区二区三区|
国产一区二区三区免费视频|
丝袜美腿一区|
日本一区二区在线观看视频|
午夜影院久久久|
色吊丝在线永久观看最新版本|
日本a级片在线观看|
国产成人免费av在线|
日韩在线综合网|
中文字幕av一区二区三区四区|
91精品人妻一区二区三区蜜桃欧美
|
欧美美女一区二区在线观看|
fc2在线中文字幕|
欧美日本视频在线观看|
91麻豆国产香蕉久久精品|
成年人三级网站|
精品国产中文字幕|
亚洲在线成人|
欧美 日韩 国产 成人 在线|
91禁国产网站|
国产成人精品一区二区免费看京|
日韩大片免费在线观看|
精品小视频在线|
亚洲女同av|
欧美 变态 另类 人妖|
日韩欧美aaa|
日本黄色片在线观看|
国产探花在线看|
一区二区三区免费看视频|
最新国产在线|
欧美视频在线观看网站|
国产女人aaa级久久久级|
国产女优裸体网站|
黄色小视频大全|
91香蕉视频污|
色成人亚洲网|
在线观看亚洲视频啊啊啊啊|
成人激情黄色小说|
www.超级碰|
在线观看日韩片|
99国内精品久久|
99免费视频|
国产性生活免费视频|
久久久www免费人成精品|
av电影资源|
日本熟妇人妻xxxx|
日本一区二区三区久久久久久久久不|
免费毛片aaaaaa|
欧美一区二区激情|
中文字幕巨乱亚洲|
中文在线√天堂|
日韩视频第二页|
亚洲乱码国产乱码精品精可以看|
欧美日韩免费做爰大片|
色悠悠久久综合网|
精品久久久在线观看|
男人影院在线观看|
无套内谢丰满少妇中文字幕
|
22288色视频在线观看|
无码播放一区二区三区|
亚洲特黄一级片|
青青草在线免费观看|
亚洲精品视频导航|
无码av免费一区二区三区试看|
嫩草在线视频|
无码一区二区精品|
欧美一级视频精品观看|
韩日精品一区|
精品无码一区二区三区电影桃花
|
99精品国产热久久91蜜凸|
免费人成短视频在线观看网站|
色综合久久久久无码专区|
一区二区高清免费观看影视大全|
欧美精品日韩少妇|